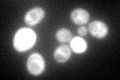
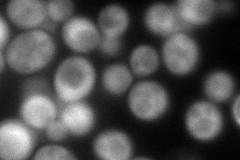
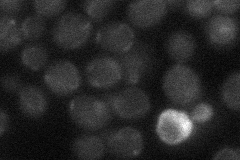
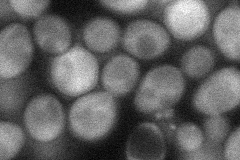

View description
Essential iron-sulfur protein required for ribosome biogenesis and translation initiation; facilitates binding of a multifactor complex (MFC) of translation initiation factors to the small ribosomal subunit; predicted ABC family ATPase
Localization:
Intensity:
Fold change:
Significance:
-
C’ GFP library in SD
cytosol139.32 -
N' NOP1pr-GFP in SD

cytosol190.549 -
N' TEF2pr-mCherry in SD
cytosol163.151 -
N' NATIVEpr-GFP in SD
below threshold18.3588 -
N' TEF2pr-VC and Cyto-VN in SD
cytosol53.8048 -
C’ GFP library in SD+DTT

cytosol111.550.8No -
C’ GFP library in SD+H2O2

cytosol144.081.03No -
C’ GFP library in Starvation Media

cytosol92.940.66No -
C’ GFP library on the background of Pup2-DaMP

cytosol -
C’ GFP library on the background of CCT mutant

cytosol125.8170.903062No
